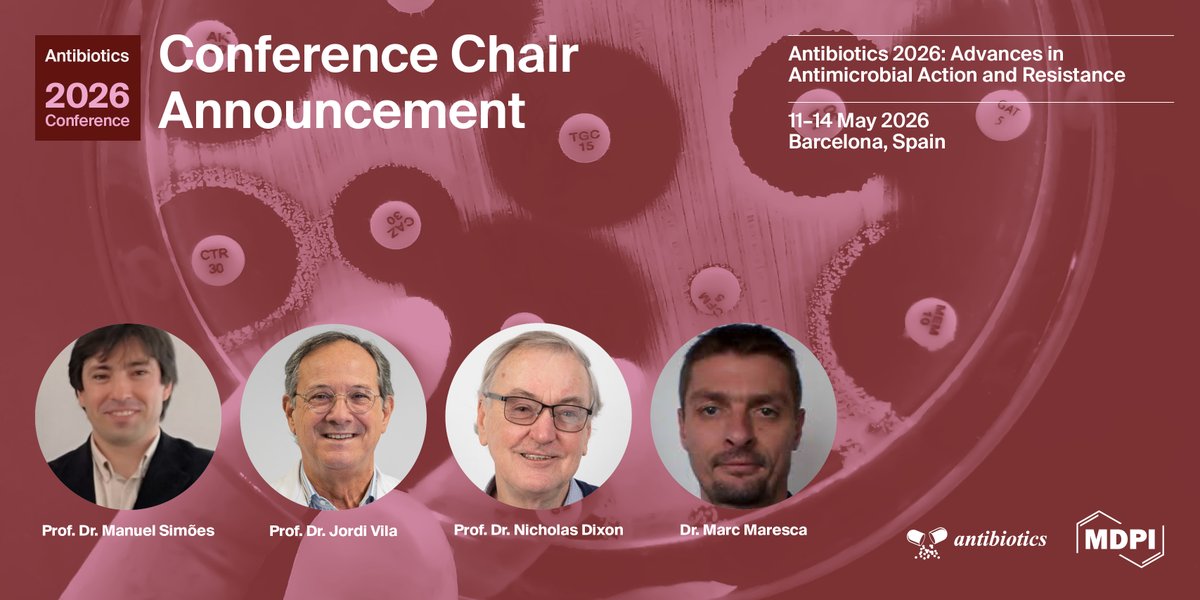

Pharmaceuticals MDPI
@pharmaceut_mdpi
Pharmaceuticals (ISSN 1424-8247): open access journal of @medicinal_chemistry and related @drug_sciences. Editor-in-Chief: Prof. Dr. Amélia Pilar Rauter
ID: 4924144308
http://www.mdpi.com/journal/pharmaceuticals 18-02-2016 06:13:26
5,5K Tweet
1,1K Followers
631 Following



📢#Specialissue: Applications of #Pharmacogenomics in #Precision #Medicine ⏰Deadline: 28 February 2026 🎓Guest Editors: Dr. Kariofyllis Karamperis, Dr. Branka Zukic and Dr. Fernanda Rodrigues-Soares 📖Find out more at mdpi.com/journal/pharma… MDPI Biology


📢#Specialissue: #Innovative Applications and Performance Optimization of #Biodegradable #Polymers in #Drug #Delivery ⏰Deadline: 25 February 2026 🎓Guest Editors: Dr. Nikolaos D. Bikiaris 📖Find out more at mdpi.com/journal/pharma… MDPI Biology


📢#Specialissue: Self-Assembling #Nanostructures for #Cancer Therapy ⏰Deadline: 25 February 2026 🎓Guest Editors: Prof. Dr. André Moreni Lopes 📖Find out more at mdpi.com/journal/pharma… MDPI Biology




📢#Specialissue: #Pharmacotherapy of #Inflammatory #Bowel Disease, 2nd Edition ⏰Deadline: 25 January 2026 🎓Guest Editors: Prof. Dr. Wolfgang Kruis 📖Find out more at mdpi.com/journal/pharma… MDPI Biology



📢#Specialissue: #Pharmaceutical Applications of #Cannabinoids ⏰Deadline: 25 June 2026 🎓Guest Editors: Dr. Eduarda M. P. Silva and Dr. Eduarda M. P. Silva 📖Find out more at mdpi.com/journal/pharma… MDPI Biology



Pharmaceuticals is a peer-reviewed, open access journal of medicinal chemistry and related drug sciences, published monthly online by MDPI. Explore below a curated collection of Editors Choice articles published in Pharmaceuticals MDPI. 👇

![Pharmaceuticals MDPI (@pharmaceut_mdpi) on Twitter photo Welcome to read the #HighlyCited paper #Pharmaceuticals
[68Ga]Ga-FAPI-46 PET/CT for Staging Suspected/Confirmed Lung Cancer: Results on the Surgical Cohort Within a Monocentric Prospective Trial by Zanoni et al.
Enjoy reading:
mdpi.com/1424-8247/17/1… Welcome to read the #HighlyCited paper #Pharmaceuticals
[68Ga]Ga-FAPI-46 PET/CT for Staging Suspected/Confirmed Lung Cancer: Results on the Surgical Cohort Within a Monocentric Prospective Trial by Zanoni et al.
Enjoy reading:
mdpi.com/1424-8247/17/1…](https://pbs.twimg.com/media/GxkWkNtbsAASEJm.jpg)








